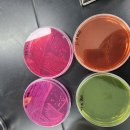
재미있는 미생물강의 이미지

카페검색 본문
카페글 본문
-
해당카페글 미리보기
-
글로벌인재개발연구원 - 2026년 강의 예약 현황 2025.12.09해당카페글 미리보기
설정 ▸교직원연수, 학부모연수, 교육청연수, 기업연수 등 √ 재미있는 강의 √ 역동적인 강의 √ 감동있는 강의 √ 내면의 에너지를 발산하는 강의 √ 변화있는 강의...입니다. 박진감 있는 Action Learning 프로그램입니다. 희열을 느끼게 합니다. 내면의...
-
○●재미있는 개인레슨 수강 후기 2025.11.18해당카페글 미리보기
수있는 루틴으로 해야한다 시며 원장님이 집접 실전적 시범을 루틴 외우라고 시범 보이시는 아래 사진입니다 시범 보이시고는 혼자 해보라며 제몸을 손으로 밀며 돌리며 다리를 더밀라시며 뻗으라며 허리는 세우고 머리는 먼곳을 보라시며 제몸을 밀고...
-
2025년 11월10일 4주차 유영주 강사님의 재미있는 공동체 놀이 강의 2025.11.23해당카페글 미리보기
-
성희롱.성폭력 예방교육 및 직장 내 괴롭힘 예방교육_김해시청 직원 대상_강의 잘하는 정승호 강사 2025.12.05해당카페글 미리보기
성희롱.성폭력 예방교육 및 직장 내 괴롭힘 예방교육_김해시청 직원 대상_강의 잘하는 정승호 강사 안녕하세요. 재미있는 교육컨설팅입니다^^ 강의 잘 하는 정승호 강사님의 오늘 소개드릴 강의는 성희롱 예방교육, 성폭력 예방교육, 직장 내 괴롭힘 예방...
-
유식철학 2회차(제3강) 강의 후기 2025.10.23해당카페글 미리보기
밝혀낸 심별체설로 발달된 심리학을 보여줍니다. 4회차에서는 심왕법에 대해 이어서 배워보겠습니다. 조금 어렵지만 재미있는 강의였습니다. 들을 때는 이해되는 것 같고 쉬웠는데 설명하려니 어렵네요.ㅎㅎ 그래서 앞으로의 강의가 더 기대됩니다. 이해...
-
처음 듣는 형소법, 재미있고 쉽게! 해커스공무원 백강현 기본이론 강의 오픈! 2025.10.08해당카페글 미리보기
큰 형사소송법, 처음부터 복잡하고 어렵게 접근하면 흥미를 잃기 쉽습니다. 해커스공무원 백강현 교수의 형사소송법 기본이론 강의는 ▶ 초시생 눈높이에 딱 맞춘 설명 ▶ 사례와 판례 중심의 쉬운 해석 ▶ 이해와 암기를 동시에 잡을 수 있는 강의력으로...
-
재미있는 미생물강의 2025.02.20해당카페글 미리보기
해당교육 당일날, 현장에서 '파워리뷰어'로 선정된 분의 후기작성에 한하여 경품을 제공해드리고 있으니 참고바랍니다. *교육날짜 : 2025년 2월18일~2월20일 *교육장소 : 한국식품정보원 *교육명 : 병원성미생물3종 *성함 : 윤정원 (성함을 남겨주셔야...
-
개그맨 윤형빈씨의 재미난 강의한번 들으러가볼까요^^ 2025.08.29해당카페글 미리보기
도시에 있는 청소년수련관에서 양성평등 주간 행사가 있답니다~^^ 좋은시간 되실것이니 이웃분들과 함께 잠시 들르셔서 재미난 이야기 강의로 함께 들어보셨으면 정말 좋겠습니다^^ 꼭들 다음주 화요일 청소년수련관으로 놀러오셔서 행사같이 즐겨보아요~~^^
-
[무역은 리스크 관리다] 새콤달콤 재미있는 무역리스크 비책(30) 상사중재에 대한 오해와 이해 2025.08.18해당카페글 미리보기
[무역은 리스크 관리다] 새콤달콤 재미있는 무역리스크 비책(30) 상사중재에 대한 오해와 이해 새콤달콤 재미있는 무역리스크 비책(30) 상사중재에 대한 오해와 이해 필자는 중재인으로 강의나 기고를 통해 중재의 중요성을 역설하고 있다. 그러나...